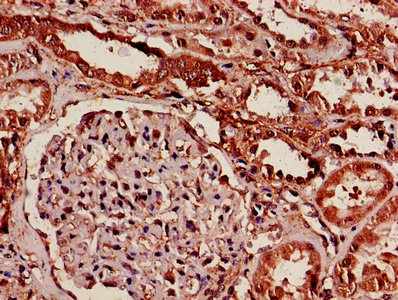

-
中文名稱:YWHAB兔多克隆抗體
-
貨號:CSB-PA01544A0Rb
-
規格:¥440
-
圖片:
-
Western Blot
Positive WB detected in: Jurkat whole cell lysate, HepG2 whole cell lysate, HL60 whole cell lysate, Rat brain tissue, Rat kidney tissue, Mouse kidney tissue
All lanes: YWHAB antibody at 4µg/ml
Secondary
Goat polyclonal to rabbit IgG at 1/50000 dilution
Predicted band size: 29, 28 kDa
Observed band size: 29 kDa -
IHC image of CSB-PA01544A0Rb diluted at 1:600 and staining in paraffin-embedded human kidney tissue performed on a Leica BondTM system. After dewaxing and hydration, antigen retrieval was mediated by high pressure in a citrate buffer (pH 6.0). Section was blocked with 10% normal goat serum 30min at RT. Then primary antibody (1% BSA) was incubated at 4°C overnight. The primary is detected by a biotinylated secondary antibody and visualized using an HRP conjugated SP system.
-
IHC image of CSB-PA01544A0Rb diluted at 1:600 and staining in paraffin-embedded human testis tissue performed on a Leica BondTM system. After dewaxing and hydration, antigen retrieval was mediated by high pressure in a citrate buffer (pH 6.0). Section was blocked with 10% normal goat serum 30min at RT. Then primary antibody (1% BSA) was incubated at 4°C overnight. The primary is detected by a biotinylated secondary antibody and visualized using an HRP conjugated SP system.
-
Immunofluorescence staining of HepG2 cells with CSB-PA01544A0Rb at 1:200, counter-stained with DAPI. The cells were fixed in 4% formaldehyde, permeabilized using 0.2% Triton X-100 and blocked in 10% normal Goat Serum. The cells were then incubated with the antibody overnight at 4°C. The secondary antibody was Alexa Fluor 488-congugated AffiniPure Goat Anti-Rabbit IgG(H+L).
-
-
其他:
產品詳情
-
產品名稱:Rabbit anti-Homo sapiens (Human) YWHAB Polyclonal antibody
-
Uniprot No.:
-
基因名:
-
別名:14 3 3 antibody; 14 3 3 protein beta antibody; 14 3 3 protein beta/alpha antibody; 14 3 3 protein zeta antibody; 14 3 3 zeta antibody; 14-3-3 protein beta/alpha antibody; 14-3-3 protein/cytosolic phospholipase A2 antibody; 1433B_HUMAN antibody; GW128 antibody; HS1 antibody; KCIP 1 antibody; KCIP-1 antibody; MGC111427 antibody; MGC126532 antibody; MGC138156 antibody; N-terminally processed antibody; Protein 1054 antibody; Protein kinase C inhibitor protein 1 antibody; Tyrosine 3-monooxygenase/tryptophan 5-monooxygenase activation protein; delta polypeptide antibody; Tyrosine 3/tryptophan 5 -monooxygenase activation protein; zeta polypeptide antibody; YWHAB antibody; YWHAD antibody; YWHAZ antibody
-
宿主:Rabbit
-
反應種屬:Human, Mouse, Rat
-
免疫原:Recombinant Human 14-3-3 protein beta/alpha protein (1-246AA)
-
免疫原種屬:Homo sapiens (Human)
-
標記方式:Non-conjugated
本頁面中的產品,YWHAB Antibody (CSB-PA01544A0Rb),的標記方式是Non-conjugated。對于YWHAB Antibody,我們還提供其他標記。見下表:
-
克隆類型:Polyclonal
-
抗體亞型:IgG
-
純化方式:>95%, Protein G purified
-
濃度:It differs from different batches. Please contact us to confirm it.
-
保存緩沖液:Preservative: 0.03% Proclin 300
Constituents: 50% Glycerol, 0.01M PBS, PH 7.4 -
產品提供形式:Liquid
-
應用范圍:ELISA, WB, IHC, IF
-
推薦稀釋比:
Application Recommended Dilution WB 1:500-1:5000 IHC 1:500-1:1000 IF 1:200-1:500 -
Protocols:
-
儲存條件:Upon receipt, store at -20°C or -80°C. Avoid repeated freeze.
-
貨期:Basically, we can dispatch the products out in 1-3 working days after receiving your orders. Delivery time maybe differs from different purchasing way or location, please kindly consult your local distributors for specific delivery time.
-
用途:For Research Use Only. Not for use in diagnostic or therapeutic procedures.
相關產品
靶點詳情
-
功能:Adapter protein implicated in the regulation of a large spectrum of both general and specialized signaling pathways. Binds to a large number of partners, usually by recognition of a phosphoserine or phosphothreonine motif. Binding generally results in the modulation of the activity of the binding partner. Negative regulator of osteogenesis. Blocks the nuclear translocation of the phosphorylated form (by AKT1) of SRPK2 and antagonizes its stimulatory effect on cyclin D1 expression resulting in blockage of neuronal apoptosis elicited by SRPK2. Negative regulator of signaling cascades that mediate activation of MAP kinases via AKAP13.
-
基因功能參考文獻:
- 14-3-3beta protein activates Pseudomonas exotoxin-S and exotoxin-T ADP-ribosyltransferase domains by chaperoning their hydrophobic surfaces independently of the amphipathic C-terminal segment. PMID: 30224724
- Data show that 14-3-3beta protein augmented the expression of matrix metalloproteinasea MMP2 and MMP9 through PI3 kinase/Akt protein/NF-kappaappa B pathway, thereby enhancing the invasiveness of hepatocellular carcinoma (HCC) cells. PMID: 26730736
- These findings indicate that 14-3-3beta and gamma are novel PPARgamma2 regulators and are involved in hepatic lipid metabolism. 14-3-3b and gamma can be therapeutic target molecules to treat non-alcoholic fatty liver disease. PMID: 26260846
- miR-152 controls both the expression of 14-3-3beta and HLA-G and exerts a dual role in tumor cells by both altering the immunogenicity and the tumorigenicity PMID: 25228695
- Data suggest that serum 14-3-3beta concentrations may constitute a useful marker for blood brain barrier damage severity and follow up in patients with eosinophilic meningitis caused by Angiostrongylus cantonensis. PMID: 24555778
- Using gene reporter assays, we show that promoter variations in 11 intrinsic apoptosis genes, including ADPRT, APAF1, BCL2, BAD, BID, MCL1, BIRC4, BCL2L1, ENDOG, YWHAB, and YWHAQ, influence promoter activity in an allele-specific manner. PMID: 24038028
- Crystal structure of Myo1c/14-3-3beta complex, which has been implicated in the exocytosis of glucose transporter 4 storage vesicles during insulin-stimulated glucose uptake. PMID: 24636949
- Data identified three classes of 14-3-3 targets that all have two binding sites, but displayed synergistic interaction between converging signalling pathways for different ranges of parameter values. PMID: 24269229
- These results indicate that the six YWHAB polymorphisms are not associated with the genetic susceptibility to sporadic Creutzfeldt-Jakob disease. PMID: 23053962
- 14-3-3beta binding to phosphorylated CFTR augments its biogenesis by reducing retrograde retrieval of CFTR to the endoplasmic reticulum. This mechanism permits cAMP/PKA stimulation to make more CFTR available for anion secretion. PMID: 22278744
- Data identified 14-3-3beta as a prognostic biomarker. PMID: 22125622
- Modulation of matrix metalloproteinase 1 by 14-3beta/alpha, may be important in the alteration of collagenase production associated with airway remodelling in obstructive lung diseases PMID: 21948273
- Analyses show that high cytoplasmic levels of 14-3-3beta and epsilon independently correlate with poor disease-specific survival in vulvar squamous cell carcinoma cases. PMID: 21935479
- In glioblastoma PTPIP51 expression increases with the grade of malignancy and PTPIP51 interacts in situ with 14-3-3ss and PTP1B. PMID: 21972092
- Studies indicate that Akt phosphorylates acetylated-FoxO and then phosphorylated FoxO interacts with 14-3-3 proteins in the nucleus, which in turn results in cytoplasmic retention of FoxO. PMID: 21396404
- Studies indictet that the mammalian FoxO family consists of FoxO1, 3, 4 and 6 and are regulated by by AKT and 14-3-3 proteins. PMID: 21708191
- The expression levels of 14-3-3 protein beta/alpha were higher in urine samples from patients with renal cell carcinoma than in samples from healthy volunteers. PMID: 21553213
- Data indicate that gene analysis revealed an up-regulation of all four 14-3-3 isoforms beta, eta, gamma, and sigma. PMID: 21416292
- 14-3-3beta protein has the potential to be used as a diagnostic and prognostic biomarker in gastric cancer. PMID: 21598387
- 14-3-3beta interacts with human Dapper1, attenuating the ability of hDpr1 to promote Dishevelled (Dvl) degradation, thus enhancing Wnt signaling PMID: 21262972
- protein within PIV5-infected cells is phosphorylated at residue S369, binds the 14-3-3 protein, and is held away from sites of virus budding. PMID: 21147917
- 14-3-3 eta, beta, gamma and sigma isoforms were negatively expressed in meningioma PMID: 20388496
- Show that viral infection activates 14-3-3 protein mediated signaling pathways in human keratinocytes. PMID: 20070120
- Study identified an overrepresentation of focal amplifications of known (FGFR3, CCND1, MYC, MDM2) and novel candidate genes (MYBL2, YWHAB and SDC4) in stage Ta bladder carcinoma. PMID: 19821490
- 14-3-3beta, 14-3-3gamma, 14-3-3epsilon, 14-3-3eta and 14-3-3theta isoforms interact with the GPIb-IX complex in platelets PMID: 19558434
- Results show that three 14-3-3 isoforms, beta, gamma and eta, are DAL-1/Protein 4.1B-binding proteins. PMID: 11996670
- TSC2 associates with 14-3-3 in vivo PMID: 12364343
- KCNK3 potassium channels are shown to bear two cytoplasmic trafficking motifs: an N-terminal dibasic site that binds beta-COP to hold channels in ER and a C-terminal "release" site that binds the ubiquitous intracellular regulator 14-3-3beta PMID: 12437930
- 14-3-3 beta interacts with the TSC1-TSC2 complex and negatively regulates the function of the TSC proteins PMID: 12468542
- 14-3-3 binds to the IGF-1 receptor after IGF1R's serine autophosphorylation PMID: 12482592
- MK2 phosphorylates TSC2, which creates a 14-3-3 binding site and thus regulates the cellular function of the TSC2 tumor suppressor protein PMID: 12582162
- 14-3-3beta is a p90 ribosomal S6 kinase (RSK) isoform 1-binding protein that negatively regulates RSK kinase activity PMID: 12618428
- Immunoexpression of 14-3-3 proteins in glial cytoplasmic inclusions of multiple system atrophy. PMID: 12669242
- These findings suggest that deregulation of 14-3-3 protein amounts might contribute to the development of tumors in tuberous sclerosis patients. PMID: 14680818
- HS1 with EPEP insertion polymorphism transmits accelerated signals from B cell receptor and is involved in pathogenesis of systemic lupus erythematosus. PMID: 15022330
- novel binding site on 14-3-3 for integrin beta1 and a functional amphipathic groove, rather than its interaction with integrin beta1, is required for 14-3-3 regulation of cell spreading and migration. PMID: 15389601
- decreased expression of selected 14-3-3 genes is a common feature of schizophrenia PMID: 15726117
- These data show a novel interaction for 14-3-3 with NFL mRNA, and suggests that 14-3-3 may play a role in regulating NFL mRNA stability. PMID: 17098443
- 14-3-3beta binds DYRK1A PMID: 17229891
- PBF is a new cellular factor mediating the effects of PI3K/Akt signaling and 14-3-3 on cell growth PMID: 17531190
- Ror2 induces osteogenic differentiation, at least in part, through a release of the 14-3-3beta-mediated inhibition PMID: 17717073
- A new regulatory mechanism of myosin light-chain phosphatase via the interaction between 14-3-3 and MYPT1, is reported. PMID: 18094049
- changes in the expression of five 14-3-3 isoforms (beta, gamma, epsilon, tau, and zeta) during the apoptosis of JURL-MK1 and K562 cells. PMID: 19173300
- Tyrosine 3-monooxygenase/tryptophan S-monooxygenase activation protein, beta polypeptide is decreased during acute lung injury more in mice deficient in metallothionein 1/2 PMID: 16166738
顯示更多
收起更多
-
亞細胞定位:Cytoplasm. Melanosome.
-
蛋白家族:14-3-3 family
-
數據庫鏈接:
Most popular with customers
-
-
YWHAB Recombinant Monoclonal Antibody
Applications: ELISA, WB, IHC, IF, FC
Species Reactivity: Human, Mouse, Rat
-
Phospho-YAP1 (S127) Recombinant Monoclonal Antibody
Applications: ELISA, WB, IHC
Species Reactivity: Human
-
-
-
-
-